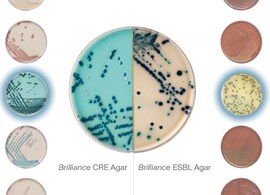
Custom bi-plate workflow Custom bi-plate workflow

Search
Search
When you're processing clinical samples, it's always best to learn as much as you can as quickly as you can to support decisions on optimal patient care. That's why we bring together some of the most widely used, high-performance culture media formulations, including our chromogenic media with patented technology, and put them side by side on our range of prepared media bi-plates. By improving your workflow efficiency across manual and automated systems, our goal is to help you do more, learn more and grow more with less.
Clinical laboratories worldwide are increasingly challenged to provide fast, actionable results while operating with staff, space and budget constraints. Thermo Scientific™ Oxoid™ and Thermo Scientific Brilliance™ agar bi-plates can simplify your workflow and help to double your output.
Do you need to be more efficient and increase the productivity in your routine lab while reducing costs? Watch now to find out how Thermo Scientific™ bi-plates can help address these challenges.
Selective media that detects multidrug-resistant organisms (MDROs).
Combining traditional media with easy-to-interpret chromogenic media for efficient high-volume urine testing.
A wide range of stool-specific bi-plates to simplify your stool sample testing.
Learn how you can tailor your screening process, reduce hands-on time and expedite pathogen identification with our extensive bi-plate range in our easy to follow guide. With workflows for common sample types and guidance on selecting the optimal media, download the guide to see how bi-plates could address your testing challenges.
Does your laboratory need a bi-plate designed specifically for a specialized application and workflow? All of our Thermo Scientific Oxoid and Brilliance media can be put into a bi-plate format that works best for you. Simply, select your media, agree specifications, test your first batch, and receive your custom bi-plates in just 8-12 weeks.
Read how one of the United Kingdom’s largest teaching hospitals, St. George’s Hospital, has been able to drive efficiencies by achieving a more complete clinical picture from a single sample with the Thermo Scientific™ Oxoid™ Columbia CNA Agar/Brilliance™ GBS Agar Biplate, which they are using to screen Group B Streptococci (GBS) and Gram positive organisms on a single plate.
“Instead of having two plates, a CNA plate and a Group B strep plate, we have half, so we are producing half of the waste, half the storage.” Senior Scientist, Shelley Bray.
Reduce waste and simplify the process for QC testing of incoming goods with the Thermo Scientific™ Tailored Delivery System (TDS), a new resusable trolley-based delivery and storage solution for Thermo Scientific™ Oxoid™ prepared culture media. This system will improve your demand planning and optimize daily usage of culture media by reducing your hands-on time for managing incoming culture media deliveries.
“We can scan the stock directly into our logistics system and check the incoming goods very easily … I can see from one look how much I have and what kind of products.” Cornelia Quandt, the Quality Manager, Laboratory Mönchengladbach Medical Care Center, Mönchengladbach, Germany.
Download the prepared media selection guide and use it to discover what we can offer to ensure maximum testing flexibility. Organized by organism type and by functionality, we have plates, bottles, bagged media, dip-slides, diluents and more. Take a look and find the right product to solve your next challenge.
Identify infections and antimicrobial susceptibility quickly and accurately to guide optimal patient care with powerful manual and automated technologies, and a comprehensive line of media.